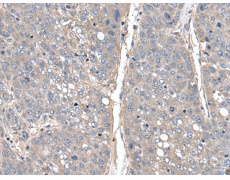
一抗

|
Background: |
This gene encodes a member of a family of proteins sharing an N-terminal Thanatos-associated domain. The Thanatos-associated domain contains a zinc finger signature similar to DNA-binding domains. This gene is part of a bidirectional gene pair on the long arm of chromosome 15 that is regulated by estrogen and may play a role in breast cancer. |
|
Applications: |
ELISA, IHC |
|
Name of antibody: |
THAP10 |
|
Immunogen: |
Full length fusion protein |
|
Full name: |
THAP domain containing 10 |
|
SwissProt: |
Q9P2Z0 |
|
ELISA Recommended dilution: |
5000-10000 |
|
IHC positive control: |
Human liver cancer |
|
IHC Recommend dilution: |
30-150 |

 購(gòu)物車
購(gòu)物車 幫助
幫助
 021-54845833/15800441009
021-54845833/15800441009